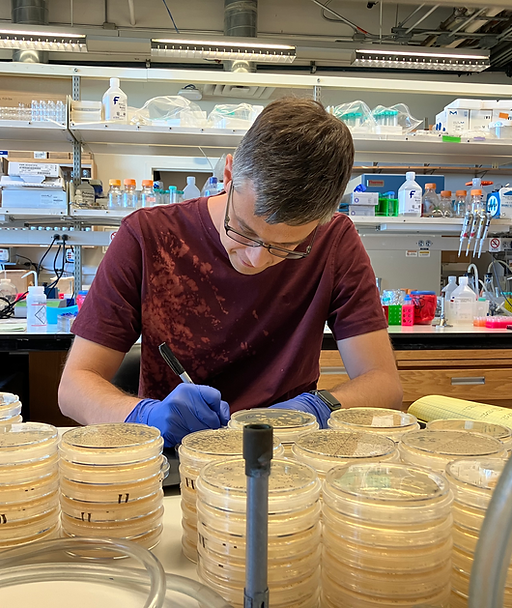
IMG_6294.HEIC

Biography
I received my PhD in Biophysics from Stanford University in 2019, where I worked in the laboratory of W. E. Moerner. While at Stanford, I explored how nanoscale structures lead to biological function. To this end, I built a STimulated Emission Depletion (STED) superresolution microscope and combined it with quantitative image analysis to study nanoscale structures in a variety of biological systems. This includes features of the primary cilium, chromatin-organizing proteins, immune receptors in human cancer tissue, and surface layers from bacteria. My graduate work has inspired novel protein engineering and deepened our understanding of nuclear organization, ciliopathies, and immunotherapies.
After graduate school, I became interested in how molecular processes affect even larger biological systems. As a postdoc in Gürol Süel's lab at UCSD, I applied techniques from systems biology first to understand how electrochemical signals modify bacterial biofilm growth by modifying gene expression. We can use these electrochemical signals to control both pathogenic and beneficial bacterial systems using novel electrochemical devices. More recently, I examined how bacterial spores use enantiomer signaling to sense and avoid competition with nearby bacterial species, suggesting novel ways to prevent food spoilage and persistent bacterial infections, where spores play an important role.
My independent research combines my expertise in molecular biophysics and systems biology with my interest in multi-species bacterial interactions to study antimicrobial resistance (AMR), one of the defining challenges of modern medicine. By studying the activation of resistance mechanisms across spatial scales and in natural environments, I will provide insight into how AMR develops in the clinic. Ultimately, my research will generate mechanistic insight that is directly translatable to novel treatment strategies, such as combination therapies or metabolic reprogramming.
Education
2012 - 2019
Stanford University
Ph.D. in Biophysics
Thesis:
Stimulated Emission Depletion Super-resolution Fluorescence Microscopy: Addressing Biophysical Questions From Bacteria to Eukaryotic Cells
2008 - 2012
University of Pennsylvania
B.A. in Physics, Biophysics, and Biochemistry